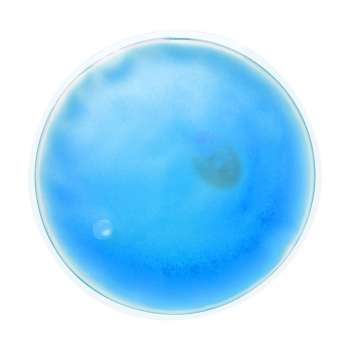
Tepelný polštářek, modrý

800 771 772 po-pá 7.30 - 17.00
OFFICEO.cz | Kancelářské potřeby
Tepelný polštářek, modrý
Kód:
Kód produktu:
QG2-516.1085
https://www.officeo.cz/tepelny-polstarek-modry/
OFFICEO.cz
Transparentní tepelný, opakované použitelný, polštářek s barevným gelem
25.41
21,00 Kč (25,41 Kč s DPH)
Ušetříte 3,10 Kč
- 17,90 Kč bez DPH
-
21,66 Kč s DPH
Skladem 6 ks
- Transparentní tepelný, opakované použitelný, polštářek s barevným gelem
- Průměr: 10 cm